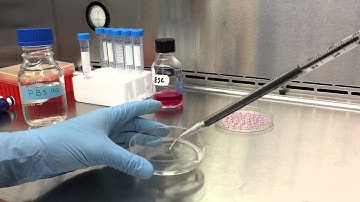
Hanging Drop Technique to Form Embryoid Bodies
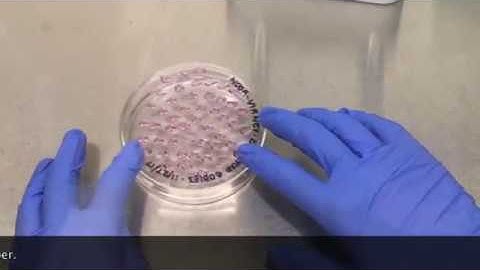
Biology 513 (Tissue culture): Hanging drops technique to form embryoid bodies

⬇ DOWNLOAD NOW
Kalau muncul iklan pop-up, tutup lalu klik tombol kembali
Download lagu Hanging Embryoid Body Technique secara gratis hanya untuk keperluan promosi. Dukung artis favorit kamu dengan membeli musik original di iTunes atau platform resmi lainnya.
 Hanging Drop Embryoid Body Formation Instructional Video
Hanging Drop Embryoid Body Formation Instructional Video
 Hanging Drop Embryoid Body Formation and Harvest
Hanging Drop Embryoid Body Formation and Harvest
 Shrinky-Dink Hanging Drops: Simple Way To Form & Culture Embryoid Bodies l Protocol Preview
Shrinky-Dink Hanging Drops: Simple Way To Form & Culture Embryoid Bodies l Protocol Preview
Hanging Drop Technique to Form Embryoid Bodies
Hanging Drop Technique to Form Embryoid Bodies
 Embryoid Body Formation Using Hanging Drop Technique
Embryoid Body Formation Using Hanging Drop Technique
Biology 513 (Tissue culture): Hanging drops technique to form embryoid bodies
Biology 513 (Tissue culture): Hanging drops technique to form embryoid bodies
 Differentiation: Mouse Embryonic Stem (mES) Cells Using Hanging Drop Method l Protocol Preview
Differentiation: Mouse Embryonic Stem (mES) Cells Using Hanging Drop Method l Protocol Preview
 Stem Cell Embryoid Body Formation
Stem Cell Embryoid Body Formation